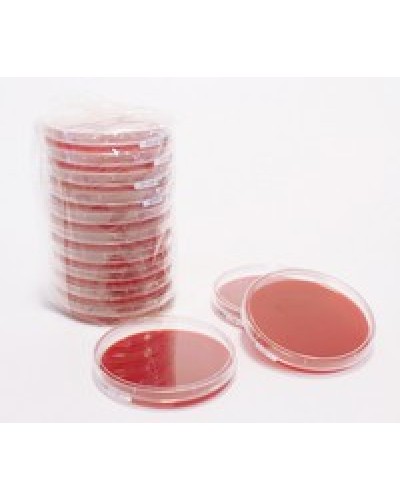
Columbia Blood Agar Pharm

Columbia Blood Agar Pharm
- Dòng sản phẩm: hoá chất tinh khiết Merck
- Số lượng sản phẩm trong kho: 1
-
0 VNĐ
Columbia Blood Agar Pharm
Code: 1465590020
Hãng sản xuất: Merck
Xuất xứ: Đức
| Tên sản phẩm: | Columbia Blood Agar Pharm |
| Tên khác: | Columbia Agar |
| Code: | 1465590020 |
| Hãng - Xuất xứ: | Merck - Đức |
| Ứng dụng: |
- Hóa chất sử dụng trong nuôi cấy vi sinh trong phòng thí nghiệm. Ứng dụng trong phân lập và nuôi cấy vi khuẩn khó tính. - Sử dụng để phát hiện tan máu. |
| Tính chất: |
- Hình thể: rắn, màu đỏ - Giá trị pH: 7.3 (H₂O) |
| Bảo quản: | Bảo quản ở nhiệt độ từ +4°C đến +12°C. |
| Quy cách đóng gói: | 20 tấm/ hộp |
Sản phẩm tham khảo:
| Code | Quy cách |
| 1465590020 | 20 tấm/ hộp |
| 1465590100 | 100 tấm/ hộp |
Xu hướng tìm kiếm: Columbia Blood Agar Pharm